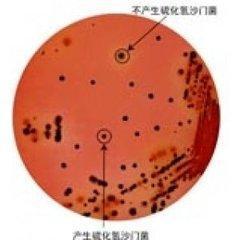
副溶血孤菌腸炎

病因
食用被腸炎弧菌污染的海鮮而發生食物中毒。
症狀
本病病程自1~6日不等,可自限,一般恢復較快。
潛伏期一般為6~20h,最短1~3h,最長可達96h。起病急驟,先以畏寒、發熱、全身不適、腹部不適開始,隨之出現上腹部、臍周陣發性絞痛,並伴有噁心、嘔吐和腹瀉。大便每天數次至20餘次不等,大便以黃色水樣便較多,少數為血水樣便,極少數呈現膿血便,但很少有里急後重感。嚴重腹瀉可導致脫水,循環衰竭,伴聲音嘶啞和肌肉痙攣,甚至出現神志意識障礙。兒童患者多以高熱起病,體溫多在38~40℃,中毒症狀顯著,腸道症狀較成人輕。本病病程3~5天,除個別老弱患者可引起死亡外,一般預後良好。國外報導,本病臨床表現除典型胃腸炎型外,尚有痢疾型、中毒性休克型,慢性腸炎型。
根據發病季節、食海製品史、集體發病,臨床表現為腹痛、腹瀉、嘔吐、腹部壓痛、血壓下降以及水樣或血水樣便、膿血黏液便等,可作出初步診斷,如從可疑食品、糞便中檢出副溶血性弧菌即可確診。
檢查
1、血象:發病初期,白細胞總數增高,多在(10~20)×109/L,分類中性粒細胞80%以上。
2、糞便鏡檢:可見白細胞或膿細胞,常伴有紅細胞,易被誤診為菌痢。糞便培養可檢出副溶血弧菌,絕大多數迅速轉陰,僅少數持續陽性2~4天。
3、細菌培養:發病1~2天,糞便培養陽性率高,2天后陽性率減低。可疑食物,如海產品、醃漬品等細菌培養,有時亦能分離出細菌。目前用VITEK-AMS微生物自動分析系統進行腹瀉患者糞便細菌分析鑑定,可準確迅速診斷。
4、聚合酶鏈反應(PCR)技術檢測副溶血性弧菌DNA該技術簡便、快速、特異、靈敏度高。
5、血清凝集試驗:患病初期血清凝集效價較高,此後大多很快轉為陰性。如效價達到1∶80~1∶160,可診斷本病。在恢復期,檢測耐熱溶血素抗體,滴度常明顯升高到1∶80~1∶160。
診斷
副溶血孤菌腸炎 根據病史和臨床表現即可初步診斷,結合細菌學檢驗可確診。
副溶血孤菌腸炎
副溶血孤菌腸炎1、病史
夏秋季節,有進食海產品、鹹菜或被海產品污染的熟食品史。
2、臨床表現
病急,潛伏期短,上腹部陣發性絞痛,並班噁心、嘔吐。
3、實驗室診斷:細菌學、血清學檢驗。
併發症
1、可並發中毒性休克:患者可表現為血壓下降,心率增快,心慌、心悸等不是症狀。
2、嚴重腹瀉可導致脫水,電解質失衡,循環衰竭:由於大量液體通過消化道丟失,如果不能及時補充充分的液體,容易引起水、電解質失衡,從而導致循環衰竭。
3、神志意識障礙:如果毒性的食物長期存在於體內,可以會通過循環進入大腦的血供,引起意識障礙,甚至出現腦死亡。
預防
預防措施與其他細菌所致者似。關鍵在於加強衛生宣傳,提高人們的衛生素質。
1、加強海產品衛生處理。對海產品清洗、鹽漬、冷藏、運輸應嚴格按衛生規定管理。
2、防止生熟食物交叉污染,不生吃海產品。做到生菜和熟菜分開,防止交叉感染。對海產品要煮熟炒透。貯存的食品在進食前要重新煮透。不吃生成蟛蜞、生梭子蟹、鹹烤蝦等,如生吃,一定要用醋泡5min,殺死病原菌。
3、控制食品中細菌生長。通常食品應放在涼爽通風處,或保存在冰櫃內。隔餐的剩菜,食前應充分加熱。不宜在室溫下放置過久。
治療
1、支持及對症治療
脫不者需輸入生理鹽水及葡萄鹽水,或口服補液鹽,以糾正失水。血壓下降者,除被補充知容量,糾正酸中毒等外,可酌用血管活性藥。
2、藥物治療
輕者患者可不用抗菌藥物,較重者可給複方新諾明或慶大黴素、阿米卡星和諾氟沙星等喹諾酮類抗菌藥物。

